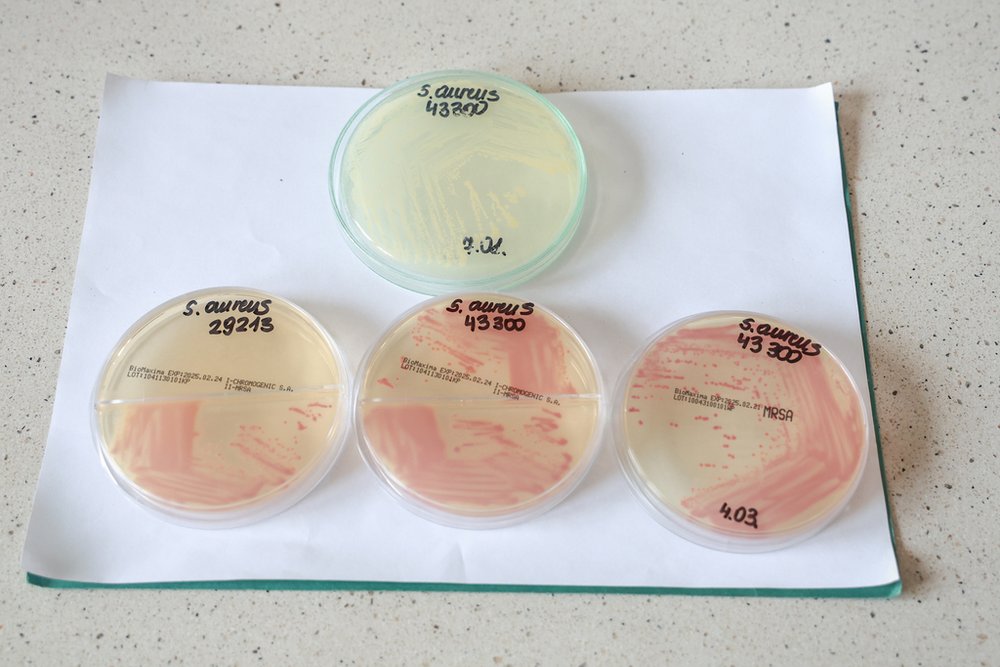
biological samples

The Deputy Mayor visited the Department of Immunology and Infection Biology, where he met with dr hab. Beata Sadowska. The meeting was also attended by Prof. dr hab. Agnieszka Marczak, Dean of the Faculty of Biology and Environmental Protection, and dr hab. Krzysztof Pabis, the University of Lodz Vice-Rector for the Popularisation of Science and Education.
During the meeting, key areas of research activities of the Department of Immunology and Infection Biology were discussed, as well as the challenges faced by modern microbiology, including the phenomenon of drug resistance of microorganisms, which is a global problem of the 21st century. There was also a discussion on the possibilities of establishing cooperation between the Faculty and the City of Lodz Office.
Source and photos: Kamila Knol-Michałowska, Promotion Centre, Faculty of Biology and Environmental Protection, University of Lodz; Wojciech Jastrzębski, City of Lodz Office